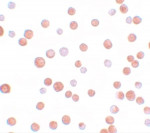

Search Result - Primary Antibodies
There are 428 results for "DNA"
- anti-CHRAC17 antibody
- Cat. No: ARG40134 (Rabbit pAb)
- Reactivity: Hu
- Application: FACS, WB
- Conjugation: Un-conjugated
- anti-POLR2I / RPB8 antibody
- Cat. No: ARG66454 (Rabbit pAb)
- Reactivity: Hu, Ms, Rat
- Application: WB
- Conjugation: Un-conjugated
- anti-CHRAC17 antibody
- Cat. No: ARG66466 (Rabbit pAb)
- Reactivity: Hu
- Application: ICC/IF, WB
- Conjugation: Un-conjugated
- anti-TCF12 antibody
- Cat. No: ARG41087 (Rabbit pAb)
- Reactivity: Hu
- Application: ICC/IF, WB
- Conjugation: Un-conjugated
- anti-BLM / Blooms Syndrome Protein antibody
- Cat. No: ARG66736 (Rabbit pAb)
- Reactivity: Hu
- Application: ICC/IF, IHC-P
- Conjugation: Un-conjugated
- anti-Rad51C antibody
- Cat. No: ARG24094 (Rabbit pAb)
- Reactivity: Hu, Mk
- Application: ICC/IF, IHC-P, WB
- Conjugation: Un-conjugated
- anti-LAGE3 antibody
- Cat. No: ARG44398 (Rabbit pAb)
- Reactivity: Hu
- Application: ICC/IF, WB
- Conjugation: Un-conjugated
- anti-APOBEC3B antibody
- Cat. No: ARG46012 (Rabbit pAb)
- Reactivity: Hu
- Application: IHC-P, WB
- Conjugation: Un-conjugated
- anti-APOBEC3G antibody
- Cat. No: ARG46013 (Rabbit pAb)
- Reactivity: Hu
- Application: IHC-P, WB
- Conjugation: Un-conjugated
- anti-CIB1 antibody [1D1]
- Cat. No: ARG56945 (Mouse mAb)
- Reactivity: Hu
- Application: WB
- Conjugation: Un-conjugated